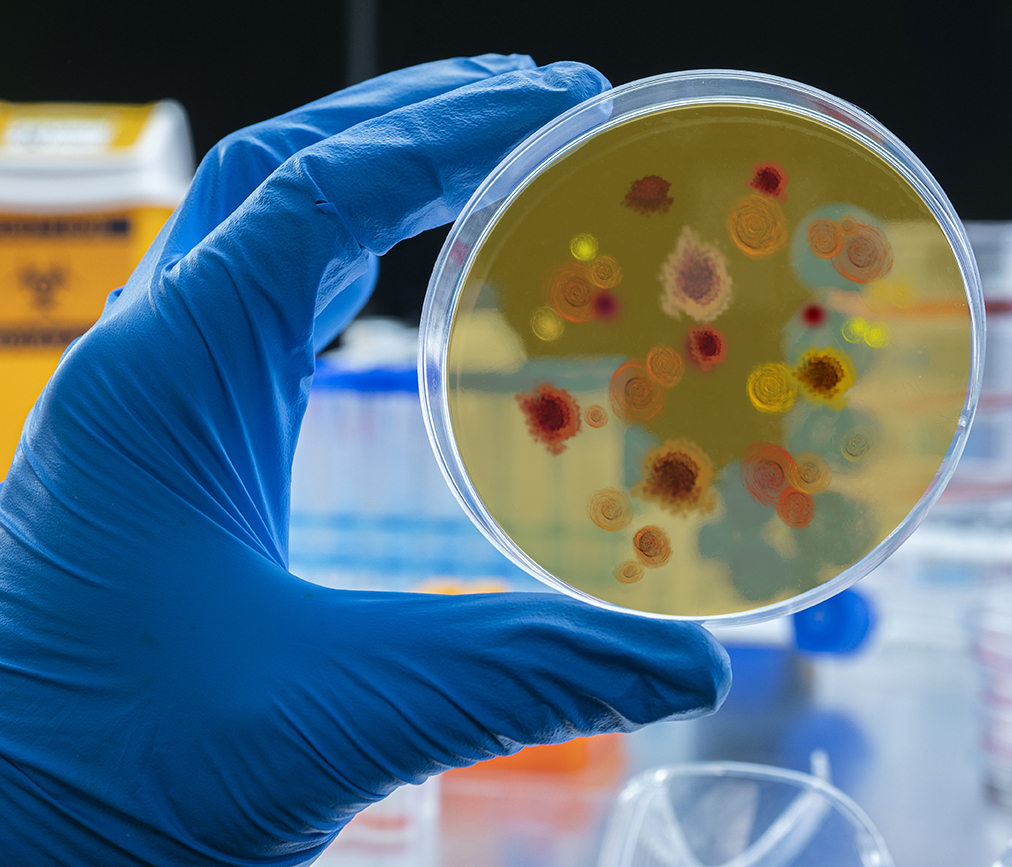
Scientist examines malaria virus on petri dish in laboratory

New antibiotic fights antimicrobial resistant bacteria
Topics Featured
Recent work published in Nature has introduced Zosurabalpin, a new antibiotic effective against Carbapenem-resistant Acinetobacter baumannii (CRAB). Developed by researchers at Harvard University and Hoffman-La Roche, this antibiotic is in a class of its own – literally. CRAB and other harmful Gram-negative bacteria are notoriously difficult to kill, in part due to the two layers of molecules called lipopolysaccharides that form a tough outer bacterial membrane. Zosurabalpin addresses this bacterial defense by inhibiting the movement of these lipopolysaccharides to the outer bacterial membrane. With nowhere to go, these molecules build up to toxic levels within the bacterial cell, causing death. No other antibiotic currently on the market functions in this way.
Want to know more about typical antibiotic strategies?
The development of a new kind of antibiotic marks an important step forward in the fight against antimicrobial resistance. Antimicrobial resistance develops when microorganisms, such as bacteria and fungi, evolve to overcome the drugs designed to kill them. These resistant bugs then populate the environments vacated by the elimination of the non-resistant strains, rendering myriad antibiotics ineffective. In a 2022 publication, The Lancet estimated that about 1.3 million people worldwide died directly from antimicrobial resistance in 2019. This is staggering when compared to the findings that, during the same year, a nearly equal amount of deaths occurred from HIV/AIDS (860,000) and malaria (640,000) combined.
When considering antibiotic-resistant Gram-negative bacteria, identifying new treatment strategies for CRAB is a top priority of the World Health Organization. The development of Zosurabalpin is an important step in the fight against these highly resistant bacteria. However, Dr. Michael Lobritz, global head of infectious disease at Roche Pharma and part of the research team, cautions those hoping that Zosurabalpin is the answer to defeating CRAB – it’s still a very formidable pathogen and this antibiotic is just a single soldier in the fight.
Zosurabalpin is now in phase 1 clinical trials to assess its safety, tolerability and efficacy in humans.
To review the original Nature article, follow this link.
Streck releases improved ARM-D Kit, OXA
